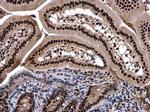
SMARCC2 Antibody in Immunohistochemistry (Paraffin) (IHC (P))

Search
Invitrogen
SMARCC2 Polyclonal Antibody
{{$productOrderCtrl.translations['antibody.pdp.commerceCard.promotion.promotions']}}
{{$productOrderCtrl.translations['antibody.pdp.commerceCard.promotion.viewpromo']}}
{{$productOrderCtrl.translations['antibody.pdp.commerceCard.promotion.promocode']}}: {{promo.promoCode}} {{promo.promoTitle}} {{promo.promoDescription}}. {{$productOrderCtrl.translations['antibody.pdp.commerceCard.promotion.learnmore']}}
图: 1 / 3
SMARCC2 Antibody (PA5-34838) in IHC (P)

产品信息
PA5-34838
宿主/亚型
分类
类型
抗原
偶联物
形式
浓度
规格
保存条件
运输条件
产品详细信息
PA5-34838 targets SMARCC2 in WB applications and shows reactivity with Human samples.
The PA5-34838 immunogen is recombinant fragment corresponding to a region within amino acids 85 and 309 of SMARCC2 (Uniprot ID#Q8TAQ2).
靶标信息
Cdc73 is a tumor suppressor probably involved in transcriptional and post-transcriptional control pathways. Cdc73 is part of the PAF1 complex, a five-subunit protein complex composed of Paf1, Cdc73, Leo1, Rtf1 and Ctr9. PAF1 was first purified from yeast in association with RNA polymerase II and is believed to function in transcription elongation. The yeast PAF (yPAF) complex interacts with RNA polymerase II and coordinates the setting of histone marks associated with active transcription. In addition to coordinating events during transcription (initiation, promoter clearance, and elongation), hPAF also coordinates events in RNA quality control. Cdc73 may also be involved in cell cycle progression through the regulation of cyclin D1/PRAD1 expression.
⚠WARNING: This product can expose you to chemicals including mercury, which is known to the State of California to cause birth defects or other reproductive harm. For more information go to www.P65Warnings.ca.gov.
仅用于科研。不用于诊断过程。未经明确授权不得转售。



